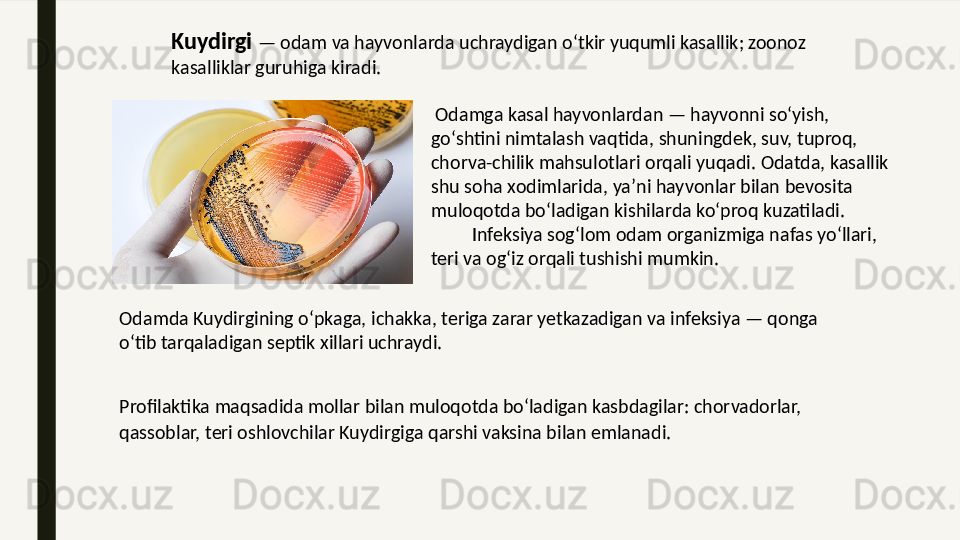

Дата регистрации 10 Май 2023
5700 ПродажQutirish, kuydirgi yara, brutselyoz, tulyaremiya

Qutirish, kuydirgi yara, brutselyoz, tulyaremiya